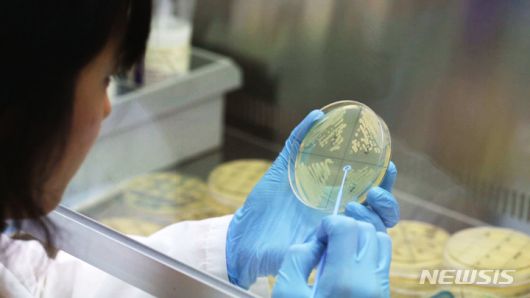
뉴시스

질병청, 병원체자원 분양 동향 및 현황 발표
논문 19건, 특허 8건 등 활용 성과 거두기도
|
[청주=뉴시스] 국립보건연구원 공공백신개발지원센터의 한 연구원이 실험용 플레이트에 병원체를 배양하는 모습. (사진=국립보건연구원 제공) 2022.11.11. photo@newiss.com |
<이미지를 클릭하시면 크게 보실 수 있습니다> |
[서울=뉴시스] 구무서 기자 = 세균과 바이러스 등 국가병원체자원이 지난해 연구 등의 목적으로 2701주가 분양됐다.
질병관리청 국립보건연구원 국가병원체자원은행은 5일 2025년 병원체자원 분양 동향 및 현황을 발표했다.
국가병원체자원은행은 국가 생명연구자원의 하나인 병원체자원을 수집·관리·분양해 감염병 분야 연구개발 및 보건의료 산업 발전을 지원하고 있다.
병원체자원이란 보건의료 연구 또는 산업을 위해 실제적이거나 잠재적인 가치가 있는 자원으로서, 인간에게 감염병을 일으키는 세균, 진균, 바이러스, 원충 등의 병원체 및 관련 정보 등이 해당한다.
2025년도에는 291개 기관에 2701주(273종) 병원체자원을 분양했으며, 그중 진균 자원의 분양이 29기관에 188주로 전년대비 대폭 증가했고(172.5%) 바이러스는 코로나19 바이러스가 141주로 가장 많이 분양됐다
자원 활용 목적을 보면 진단기술 연구가 38%로 가장 많았고 기술 및 제품 개발 연구가 22%, 백신 및 치료제 연구 18% 순으로 분양됐으며, 기술 및 제품 개발 연구가 2024년 전년 대비 분양이 110% 증가해 산업적 활용이 확대되는 추세를 보였다.
기관별로는 산업체 등 민간영리기관(47%)에 가장 많이 분양됐고, 대학 및 비영리기관(28%), 국·공립연구기관(25%)이 뒤를 이었다
분양 자원은 대장균(280주)가 가장 많았고 폐렴간균(209주), 살모넬라균(180주), 코로나19 바이러스(141주), 인플루엔자 바이러스(117주) 순이었다.
병원체자원 활용 성과로는 논문 발표(19건) 및 특허(8건) 등이 있었다.
김도근 국가병원체자원은행장은 "국가병원체자원은행은 지속적으로 국내 병원체자원의 활용이 촉진될 수 있도록 유용 자원을 개발하고 고부가가치 정보를 확보해 제공할 것"이라며 "국내·외 협력을 강화해 고품질과 수요맞춤형 자원의 확보 및 활용지원, 연구 인프라 확대를 통해 제약·의료 산업의 연구·개발 활성화와 국민 보건 향상에 기여하겠다"고 말했다.
☞공감언론 뉴시스 nowest@newsis.com
▶ 네이버에서 뉴시스 구독하기
▶ K-Artprice, 유명 미술작품 가격 공개
이 기사의 카테고리는 언론사의 분류를 따릅니다.
기사가 속한 카테고리는 언론사가 분류합니다.
언론사는 한 기사를 두 개 이상의 카테고리로 분류할 수 있습니다.
언론사는 한 기사를 두 개 이상의 카테고리로 분류할 수 있습니다.


